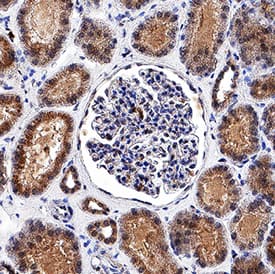

Human Cystatin C Antibody
R&D Systems, part of Bio-Techne | Catalog # MAB11963


Key Product Details
Species Reactivity
Applications
Label
Antibody Source
Product Specifications
Immunogen
Ser27-Ala146
Accession # P01034
Specificity
Clonality
Host
Isotype
Scientific Data Images for Human Cystatin C Antibody
Cystatin C in HepG2 Human Hepatocellular Carcinoma Cell Line.
Cystatin C was detected in immersion fixed HepG2 Human Hepatocellular Carcinoma Cell Line using Mouse Anti-Human Cystatin C Monoclonal Antibody (Catalog # MAB11963) at 8 µg/mL for 3 hours at room temperature. Cells were stained using the NorthernLights™ 557-conjugated Anti-Mouse IgG Secondary Antibody (red; Catalog # NL007) and counterstained with DAPI (blue). Specific staining was localized to cytoplasm. View our protocol for Fluorescent ICC Staining of Cells on Coverslips.Detection of Cystatin C in Human Kidney.
Cystatin C was detected in immersion fixed paraffin-embedded sections of Human Kidney using Mouse Anti-Human Cystatin C Monoclonal Antibody (Catalog # MAB11963) at 5 µg/mL for 1 hour at room temperature followed by incubation with the Anti-Mouse IgG VisUCyte™ HRP Polymer Antibody (Catalog # VC001). Before incubation with the primary antibody, tissue was subjected to heat-induced epitope retrieval using VisUCyte Antigen Retrieval Reagent-Basic (Catalog # VCTS021). Tissue was stained using DAB (brown) and counterstained with hematoxylin (blue). Specific staining was localized to convoluted tubules. View our protocol for IHC Staining with VisUCyte HRP Polymer Detection Reagents.Applications for Human Cystatin C Antibody
Immunocytochemistry
Sample: Immersion fixed HepG2 Human Hepatocellular Carcinoma Cell Line.
Immunohistochemistry
Sample: Immersion fixed paraffin-embedded sections of Human Kidney
Formulation, Preparation, and Storage
Purification
Reconstitution
Formulation
Shipping
Stability & Storage
- 12 months from date of receipt, -20 to -70 °C as supplied.
- 1 month, 2 to 8 °C under sterile conditions after reconstitution.
- 6 months, -20 to -70 °C under sterile conditions after reconstitution.
Background: Cystatin C
Cystatin C is a member of family 2 of the Cystatin superfamily (1). It is involved in processes such as tumor invasion and metastasis, inflammation and some neurological diseases. It inhibits many cysteine proteases such as papain and cathepsins B, H, K, L and S (2, 3). It is ubiquitous in human tissues and body fluids. A point mutation in the gene coding for the 120 amino acid mature Cystatin C causes a hereditary form of amyloid angiopathy in which the protein variant (Leu68 to Gln) is deposited in the cerebral arteries, leading to fatal cerebral hemorrhage (4). Cystatin C may have additional clinical applications. For example, it is a good marker for glomerular filtration rate (5).
References
- Reed, C.H. (2000) British J. Biomed. Sci. 57:323.
- Janowski, R. et al. (2001) Nat. Struct. Biol. 8:316.
- Abrahamson, M. (1994) Methods Enzymol. 244:685.
- Abrahamson, M. et al. (1992) Hum. Genet. 89:377.
- Laterza, O.F. et al. (2002) Clin. Chem. 48:699.
Alternate Names
Gene Symbol
UniProt
Additional Cystatin C Products
Product Documents for Human Cystatin C Antibody
Product Specific Notices for Human Cystatin C Antibody
For research use only